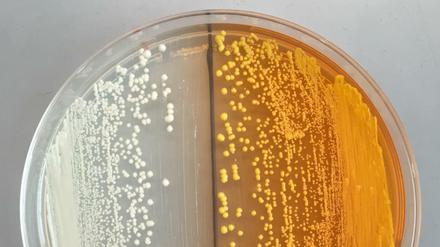

Zu wenig Mediziner: Bei der Auswahl werden zu oft die Falschen zugelassen - viele werden später nie als Arzt tätig

Zu wenig Mediziner: Bei der Auswahl werden zu oft die Falschen zugelassen - viele werden später nie als Arzt tätig

Das Zwei-Grad-Ziel ist willkürlich und zunehmend unrealistisch. Wenn überhaupt, so ist es allenfalls mit fragwürdigen Mitteln zu erreichen. Es ist Zeit, endlich ehrlich zu sein. Ein Kommentar.

Wie geht es weiter mit dem umstrittenen Deutschlandstipendium? Die Grünen wollen es abschaffen und lieber Flüchtlingen helfen. Bildungsministerin Wanka dagegen verweist auf steigende Stipendiatenzahlen.

1,8 Millionen Facebook-Likes, über 26 Millionen You-Tube-Aufrufe - auf dem Catwalk der Internetstars ist Lilbub ohne Zweifel eine Berühmtheit. Aber sie ist auch krank. Berliner Genetiker wollen jetzt das Erbgut des Katzenstars entziffern.
Morphin, Heroin - bislang werden Opiate aus Schlafmohn gewonnen. Mit einer neuartigen Hefe könnten die Drogen künftig so wie beim Bierbrauen produziert werden.

Ist das Organ verschlossen, kann sich ein unangenehmer Druck aufbauen. Mit einem Verfahren aus der Herzmedizin machen HNO-Ärzte die Ohrtrompete wieder durchgängig.
öffnet in neuem Tab oder Fenster